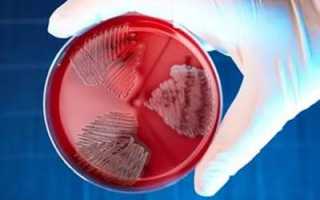
Лечение стрептококковой инфекции в урологии

Профилактика стрептококковой инфекции направлена на ранее выявление бактерии и лечение причины. Санитарно-профилактические мероприятия в обязательном порядке проводятся в медицинских, образовательных, дошкольных учреждениях и различных организациях.
Общая профилактика стрептококка включает:
- устранение очагов бактериальной инфекции – ранняя госпитализация пациентов со средней и тяжелой формой заболевания;
- наблюдение за пациентами после перенесения острых форм инфекции на протяжении 3 месяцев при роже, после ангины – 15 дней, в случае скарлатины – 25 дней;
- возвращение к привычной жизни возможно только на 12 день после выздоровления и выписки из стационара.
Своевременное принятие мер профилактики и установленных мер позволяет приостановить распространение первичных и вторичных форм стрептококковой инфекции.
Материалы по теме
Основной мерой профилактики является предотвращение контакта с больным. Дети с ангиной или воспалениями кожи не должны посещать детские коллективы пока не пройдут лечение антибиотиками.
Прививка
Эффективным средством профилактики пневмонии, которая обусловлена стрептококками, является прививка. Разработана современная и безопасная вакцина Пневмо-23 (23 – число видов стрептококка, от которых прививка защищает).
Она не включена в список обязательных прививок и подойдет для малышей старше 2-х лет, которые постоянно контактируют с людьми, имеющими ослабленный иммунитет или серьезные хронические болезни (бронхит, астма, диабет). Дети с заболеваниями почек, удаленной селезенкой, анемией также должны быть привиты от стрептококков.
Чтобы почечная инфекция не появилась, важно соблюдать простые правила гигиены, которые помогут предотвратить попадание микробов в организм. При подмывании желательно не пользоваться средствами, которые содержат отдушки, это может негативно повлиять на микрофлору. Не рекомендуется носить сильно обтягивающую и давящую одежду.
Малоподвижный образ жизни способствует застою крови и накоплению лишних килограммов. Это частая причина появления камней в мочевом пузыре, которые, в свою очередь, вызывают инфекционные заболевания почек. Нужно стараться как можно больше двигаться, ходить пешком, заниматься спортом. Не стоит запускать болезнь или заниматься самолечением.
В ходе профилактики и лечения почечных инфекций нужно употреблять как можно больше жидкости. Обильное питье вымывает из организма бактерии. Особенно полезен морс, который «окисляет» мочу и делает ее непригодной для размножения микробов. В рацион питания должны обязательно входит свежие фрукты, овощи и зелень, особенно петрушка.
Необходимо соблюдать правила индивидуальной профилактики, личной гигиены, контактируя с больными. Указанные меры подразумевают обработку поверхностей, посуды, ношение маски, мытье рук с мылом.